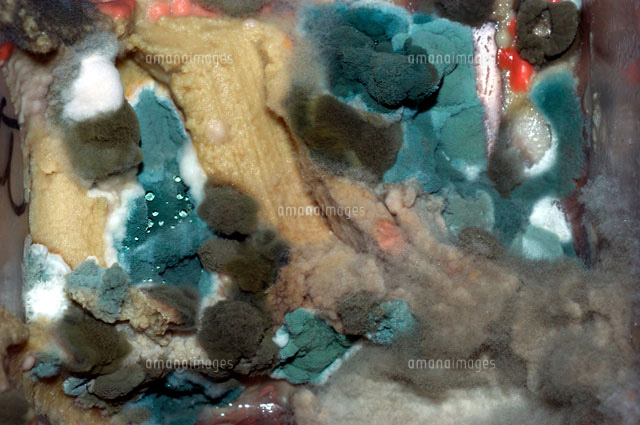
カビの生えた食べ物 の写真素材 イラスト素材 アマナイメージズ
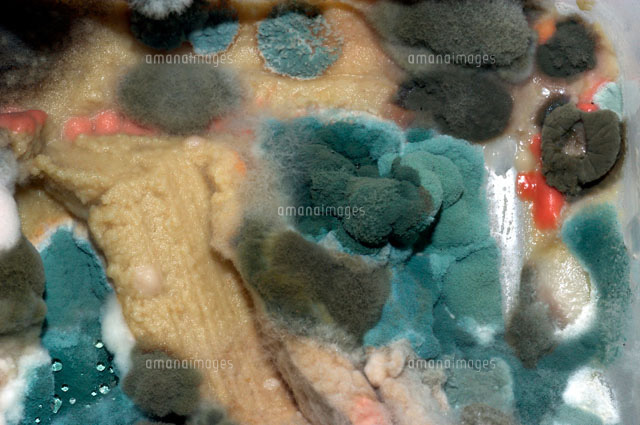
カビの生えた食べ物 の写真素材 イラスト素材 アマナイメージズ

カビの多くはpH 3~9で発育可能です。よく発育するのはpH 4~6の範囲で、弱酸性を好むものが多いようです。 5栄養分 カビの発育には当然栄養分が必要です。食品のカビは食品成分そのものが栄養となるためカビが発育すればするほど食品は劣化します。「カビの色といえば?」 おそらくほとんどの人は「黒」と答えのではないでしょうか。 しかし、カビは何万種類もあり、その種類によって色はそれぞれ違います。 カビの色がわかると「実はこれもカビだったのか!」と気づくかもしれませカビの発 生の原因となるところは、ファン自体、特にシロッコファンの羽 の間にカビがびっちりついて居る場合が多いのです。 また、空気を冷やすためのフィンとフィンの間にカビがびっち りついて居る場合もあります。

ぬか床にカビが生えた 青カビ 白カビ 取り除いてなんとか復活 ぬか漬け 健康探究ブログ
カビが生えた
カビが生えた-第10回 「カビ」レポートを作ろう! :日立ハイテク 特集第10回 「カビ」レポートを作ろう! うっかり 放置 ほうち してしまった 食 た べ 物 もの をみたら「カビ」が 生 は えていた、なんて 経験 けいけん ありませんか。 「カビ」は、おいしく 食 たお米の水分量17%を超えるとカビが生えやすくなります。 カビが生える条件 ・気温25度で発生。25度前後で活発になる。 ・湿度80%以上 ・お米の水分含有量17%以上 カビが生えているお米の特徴とは 夏場でもご購入後 1ヵ月以内で消費される方ならば、




カビを食べたらどうなるの 誤って食べた時の対処方法と身体への影響について シュフーズ
やっぱりカビって危険なの? 専門家に聞いてみた 2300;高松塚古墳石室カビ制御の問題 • 高湿環境 極めて高い湿度環境 • 環境変化 石室内での温湿度変化 • 制御の制約 十分な対応が不可 • 石室狭隘 高湿で狭い • 高度カビ 染高度カビ汚染 かなりカビ汚染が進行 • 高湿性カビ汚染 高湿性カビが主体 • 作業の効率 短時間での作業性 1番カビやすいと言われる革製品、悩んでいる方も多いのではないでしょうか? 革製のバッグのカビには上の4つの落とし方があります。 それぞれご紹介していきますね! 「天日干し」でカビを撃退! まずは1番手っ取り早いカビの落とし方をお伝えします。
このジメジメした季節に生えることから皆さんもご存知の通り カビは湿気が大好きです。 湿度60%で繁殖が活発になるそうです。 ちなみに会社の湿度をみてみると、、 70%を超えています。 梅雨時の湿度、やはりカビが繁殖するにはもってこいみたいです。 カビが生えた食べ物には、カビ以外の細菌も繁殖していることがありますよ。 Q 大腸菌のような細菌は食中毒を起こすんでしょ。 カビも体に毒な カビ mold, mildew このパンの塊にはカビが生えています。 食べないで。 There is mold growing on this loaf of bread Don't eat it カビとカビは一般的な家庭の問題です。 Mold and mildew is a common household problem 多くのスーパーマーケットの製品は、カビやカビを排除します。
ところで、カビが原因の苦情は、東京都が取り扱う食品に関する苦情の約3%を占めてい r M しかし、保健所などへ届けられる例は、全体の一部で、生産から消費までの間に、カビの発 生によって、膨大な量の食品が廃棄されているものと考えられます。壁に生えた気持ち悪いカビを一瞬で除去! 最強の技をカビ取り業者が解説 当社は、カビ取り業者として毎日数現場、問い合わせも多い時は1日で数十件頂くことも珍しくありません。 その中で最も多い問い合わせ内容は壁 になります。 そして、相談頂く 自由研究テーマとしてカビが生えにくい食品は梅干しのほかに何があるのか、カビの生え方の観察、研究方法、まとめ方についてお伝えします。 食べ物に生えるカビを防止する食品の実験基礎データ 難易度 簡単 対象 小学3年生以上 実験期間 7日 テーマ 実験 費用 0円




壁紙にカビが生えた時の除去方法とカビが発生するの原因と予防策 引越し宣言

カビの生えた食べ物 の写真素材 イラスト素材 アマナイメージズ
苔テラリウムのカビ予防と対策対策編 | ガラス容器の中でコケを育てる苔テラリウム「小さなコケの森」シリーズなど、道草michikusa/苔クリエイター 石河英作がコケ植物を中心に育てて楽しむ植物の企画販売を行っています。そのほか、苔について詳しく説明したコケ図鑑や育て方なども9,971 Daniel Kolitz Gizmodo US 原文 ( Rina Fukazu ) 生栗にカビが生えたら食べられる?まずは色をチェックしよう! 公開日 19年6月26日 / 更新日 19年6月28日




ソファにカビが生えてしまったら慌てず 擦らず 除去 予防法紹介




あなたの健康に有害であるかびの生えたパン の写真素材 画像素材 Image 1210




パンに生えたカビは食べても大丈夫 カビペディア ハーツクリーン監修年間0万人がみるカビ取り情報サイト



1




諦めるにはまだ早い 家でできる服についたカビの取り方




食器のカビの取り方 ハイターやカビキラーが使える 木のお皿は コジカジ




カビの生えたチーズは食べても大丈夫 安全な対処法を専門家が指南 Elle Digital Yahoo ニュース




家の中にカビが カビの発生条件や再発防止方法をご説明 くらしのマーケットマガジン




木製のテーブルにカビの生えたパン プレミアム写真




食べ物に生えたカビの処理方法 加熱で殺菌できるのか ライフハック 開運ラボ




カビが生えたミカン 写真素材 フォトライブラリー Photolibrary




専門家が回答 カビが生えた食品を食べてしまった時の対処法とは




ぬか床にカビが生えた 青カビ 白カビ 取り除いてなんとか復活 ぬか漬け 健康探究ブログ




カビが生えた部分を取り除けば食べても大丈夫 子育て応援サイト Cheer Days




高田延彦 カビ生えた布マスクに苦言 シャレにも笑い話にもならんが 芸能 デイリースポーツ Online




カビを食べたらどうなるの 誤って食べた時の対処方法と身体への影響について シュフーズ




カビが生えたみかんの周り 無傷なら食べれる 吸い込んだ時の害は お役立ち情報サイト Utile ユティル




餅もミカンも注意 カビは削れば食える の危険 リーダーシップ 教養 資格 スキル 東洋経済オンライン 社会をよくする経済ニュース




カビが生えた食パンのイラスト素材




開封後に生えたチーズの白カビは食べれる 削れば大丈夫 食べると身体への影響は 生活 料理 行事




サイエンスなび 身近な食品に生えるカビ




カビが生えた餅は食べられる 取り方 見分け方は 防止策や食べた時の対処法も紹介 ちそう




なぜ みかんにカビが生えるのか 暮らしのlabo博士 フジテレビ商品研究所



カビが生えた正月の餅をほっておいたら人化してた 16年09月21日の人物のボケ ボケて Bokete




カビが生えた食品 カビを取り除けば食べて良い カビ毒 に要注意 トクバイニュース




カビが生えた服はどうすればいい 対処法と予防法を詳しくご紹介 ダニよけシリカのウッディラボ 家事らくコラム




カビの生えたミカン 写真素材 フォトライブラリー Photolibrary




革靴のカビ対策 靴底や内側に生えたカビの正しい落とし方と防止法 男の靴 スニーカー All About




カビの生えたものを食べてしまった 対処法は すまいログ

カビの生えた食べ物 の写真素材 イラスト素材 アマナイメージズ




マットレスにカビが生えた そんな時の寝具のカビ対処法を伝授 Rooms ベッド マットレス




カビが生えた食糧 Falloutシリーズ攻略 人物紹介




カビ生えたパン食べちゃった D Tanidoraのブログ




布団にカビが生えた カビが生える原因と対処法を解説 コインランドリー総合サイト Laundrich




生姜に生えたカビは取り除けば食べられる 見分け方から対処方法まで シュフーズ




服に生えたカビを洗濯で落とす方法 黒カビや白カビの落とし方 引越し宣言




カビが生えた壁をきれいにリフォームしたい リフォームのことなら家仲間コム




ジュースからカビの生えた の写真素材 画像素材 Image




カビの生えた床 イメージマート



パンに生えた青カビの毒性は 食べても大丈夫なの カビの知識



カビで白いふわふわなものは体に悪い カビやすい場所は 食材に白カビが生えたら お役立ち 季節の耳より情報局




Amazon 面白いほどカビが生えないgold 0ml 掃除用品 オンライン通販




遺骨についたカビと見間違えやすいものの正体 写真あり 粉骨 散骨サービス カノン




フォールアウト4 カビが生えた食料 の効果 レシピ 入手方法 Fallout 4 攻略




カビの生えた服をクリーニングに出す時に行うべきこと カビペディア ハーツクリーン監修年間0万人がみるカビ取り情報サイト




眠っていた着物にカビが生えた 応急処置と正しい対処法 着物買取サポート



かぼちゃにカビが生えたときの対処方法は 日持ちさせる保存方法も解説 トクバイニュース




カビの生えた食べ物の捨て方のコツは 対策と部屋の臭いを取る方法も紹介 Populara



3




お餅に生えたカビの対処法 暮らしのlabo博士 フジテレビ商品研究所




テントにカビが生えた タコモアクション




カビを食べると毒 体内で増える 取り除けば大丈夫 カビ毒や食中毒について ランタン




アガベ属の投稿画像 By Sfon さん カビが生えたとかび と相談 月1月21日 Greensnap グリーンスナップ




服のカビの落とし方を徹底解説 捨てる まだ着る 再発を防ぐには 家事 オリーブオイルをひとまわし




にんにくにカビが 白 黒 緑 根や皮に生えた場合は食べられないの ヤオハピ



ハイヒールの休日 カビの生えたカバン を 復活させる




手作りみその表面にカビが生えた時の対処法 手前みそのススメ




カビの生えたニンジンから カビニンジンの焼きうどん を作って クックパッドにレシピ公開したら クックパッドからお叱りの連絡が来るまでの顛末 Togetter




カビの生えたケーキが売っていると思ったら 12年1月16日 エキサイトニュース




洗い物を放置してて食器にカビが生えた時の対処法 ためなる生活




知っておきたいカビの知識と対策 お手入れについて コーティングお役立ちガイド フロアコーティングなら業界店舗数no 1のマイスターコーティング ワックスより安全安心なフロアコーティング




緑と白の胞子でカビの生えたパンで急速に育つ の写真素材 画像素材 Image




琥珀糖にカビが 寒天で鉱物みたいな和菓子を作ったら乾燥で大失敗した話 国際結婚夫婦 椿とtaroのナチュラル生活



ブルーチーズにカビが生えたのですがこのカビは無害なカビでしょうか Yahoo 知恵袋




家の中にカビが カビの発生条件や再発防止方法をご説明 くらしのマーケットマガジン




少しだけカビが生えたパンは切り取って食べますか 実はngです こども ママ 元気




手作り味噌にカビが生えた 取り方や除去後の対処法 アレルギー娘の腸活で私も発酵




保存版 布団にカビが生えてたら カビの取り方と予防法 カジタク イオングループ




餅に生えたカビの取り方は 食べないほうがいい理由や防止策 シュフーズ




カビが生えた革製品を元通りにする方法はただ一つ




肝臓や腎臓に深刻なダメージ カビ生えた食品を絶対食べてはダメな理由 ライブドアニュース




カビの生えたパンを食べちゃった どんな問題があるの きっと誰かのためになるブログ




カビが生えた食品 カビを取り除けば食べて良い カビ毒 に要注意 トクバイニュース




食パンに生えたカビを取って食べるのは大丈夫 カビが生えにくい方法は ライフアップトピックス




かぼちゃにカビが生えたときの対処方法は 日持ちさせる保存方法も解説 トクバイニュース




除湿シートにカビが生えた 時の落とし方と今後の対策




かびの生えたパン の写真素材 画像素材 Image




大変だ指にカビが生えた なんてね 私のオススメのkaldiのサラミです すみません 暇だったのでついくだらない投稿を パパ氏 Snapdish スナップディッシュ Id Bnqiza




服のカビの落とし方を徹底解説 捨てる まだ着る 再発を防ぐには 家事 オリーブオイルをひとまわし




壁紙に生えたカビを除去する際に注意すべきこととは カビペディア ハーツクリーン監修年間0万人がみるカビ取り情報サイト




チーズにカビが生えたら 種類別の毒性や対処法は 食べたら害がある場合を解説 ちそう



プリンにカビ生えた 写真共有サイト フォト蔵




カビが生えた食べ物 大丈夫 ヨミドクター 読売新聞




手のひら細菌培養イメージモデル カビの生えた食パン付 新発売 いわさきグループ 食育sat サッと システム フードモデル情報



これが プリンにうっかりダウニーかけちゃった とか カビ生え 写真共有サイト フォト蔵




Fallout4 カビが生えた食糧 こまちゃんの宝箱



キノコの山にカビが生えたかと思ったw 18年05月27日の人物のボケ ボケて Bokete



未開封の饅頭がカビだらけだった 菓子 冷凍食品 商品q A コープこうべ 商品検査センター




カビの生えた餅は食べて大丈夫 正しい保存方法や発生メカニズムなど Yourmystar Style By ユアマイスター




カビはどこまで怖いのか 東南アジア旅行雑記




カビが生えた麺の写真素材




解説 手作りみそにカビが生えた時の対処方法 Youtube




手作り味噌にカビを生えにくくする方法 越前有機味噌蔵 マルカワみそ



カビ 種類




Moldynugget カビの生えたナゲット Funragedie Twitter



カビの生えたコルクマットの実践的なおすすめの対応策 処理方法 インテリア家具のカルチェラタン




手作り味噌に生えたカビの対処法と対策法 ピントル



苦くなったお正月の味




専門家が回答 カビが生えた食品を食べてしまった時の対処法とは




カビは移る 食べ物や場所などカビが好む環境と盲点 アンサー119



カビ 顕微鏡




カビの生えた餅は洗えば食える By 無縁者ですが 人が思うほど不幸ではありません



0 件のコメント:
コメントを投稿